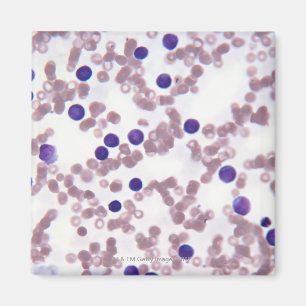
Neoplastic Lymphocyte Cells Magnet

Four types of neurons Two-Tone coffee mug
Price£16.40
Dentist Patent Poster
Price£15.70
Dentist Patent Poster
Price£15.70
Dentist Patent Poster
Price£15.70
I hate stupid people eye chart photo print
Price£42.65
Eye Test Chart Photo Print
Price£42.65
Medical Instruments Poster
Price£37.00
Cataract Surgery Mug
Price£14.75
Surgical instruments poster
Price£28.00
Medical Pain Assessment Tool Chart
Price£117.00
Blood Donor Magnet
Price£5.90
Kidney Dialysis Mug
Price£14.75
Snellen Chart Magnet
Price£5.90
Iridology Two-Tone Coffee Mug
Price£13.70
Medical Pain Assessment Tool Chart Canvas Print
Price£271.00
Pharmacy tools, pills, medication poster
Price£16.55
Anatomy of the Human Eye Magnet
Price£4.15
Intestinal Villi Magnet
Price£4.15
The Nervous System 3 Magnet
Price£4.15
Liver Transplant Magnet
Price£4.15
Cochlear Implants Magnet
Price£5.90
Syringes 3 mug
Price£14.75
Endoscopy of the Nose Mug
Price£14.75
Bones of the Foot 6 Mug
Price£14.75
Anterior Rhinoscopy Mug
Price£14.75
Liver Transplant Procedure Coaster
Price£31.90
Vertebral Column 4 Mug
Price£14.75
Cochlear Implants Magnet
Price£4.15
Liver Transplant Procedure Magnet
Price£4.15
Anatomy of Spine deformity Latte Mug
Price£21.89
Standing Biceps Curl Magnet
Price£4.15
Herpes Virus Structure 2 Two-Tone Coffee Mug
Price£13.70
Brain Arteries Two-Tone Coffee Mug
Price£13.70
Vintage WW1 Nurse Poster Apron
Price£28.45
medical floral brain anatomy poster apron
Price£29.55
Eye Test Chart Canvas Print
Price£101.70
I hate stupid people eye chart canvas print
Price£101.70
Illustration of a Hernia Coaster
Price£31.90
Liver Transplant Magnet
Price£5.90
The Vertebral Column 2 Magnet
Price£4.15
Snellen Chart Mug
Price£14.75
Dentist Tools Round Clock
Price£43.85
Fluid Flow in Chronic Glaucoma Mug
Price£14.75
Liver Transplant Two-Tone Coffee Mug
Price£13.70
Neoplastic Lymphocyte Cells Magnet
Price£4.15
Bones of the Knee 4 Mug
Price£14.75
Epidural Anaesthesia Magnet
Price£4.15
Herpes Virus Mug
Price£14.75
Medical syringe round clock
Price£44.40
The Zazzle Promise
Love It Guarantee
Don't love it? We'll take it back! 30-day returns “100% Love It Guarantee.”
Easy International Delivery
Hassle-free shipping with no surprise fees. We cover any customs & duties.
Secure Shopping Guaranteed
100% Secure payment with SSL Encryption.
Search Feedback
If you need help or have a question for Customer Service, please visit our Help Centre
Recently Viewed Items